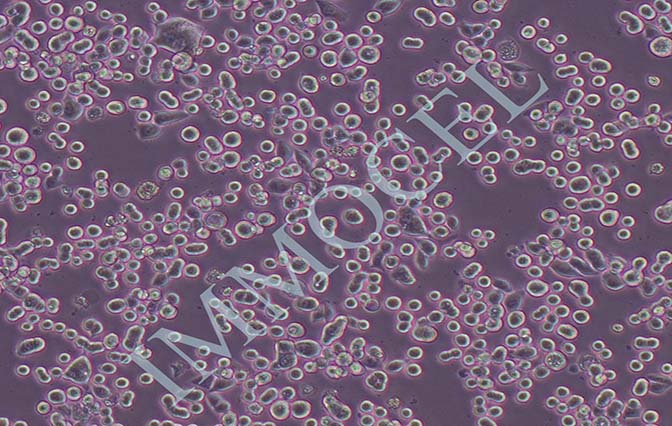
KATO III 人胃癌细胞
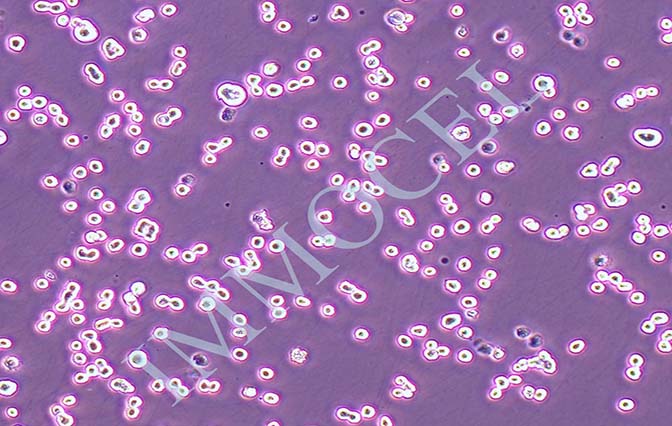
逸漠KATO III 人胃癌细胞
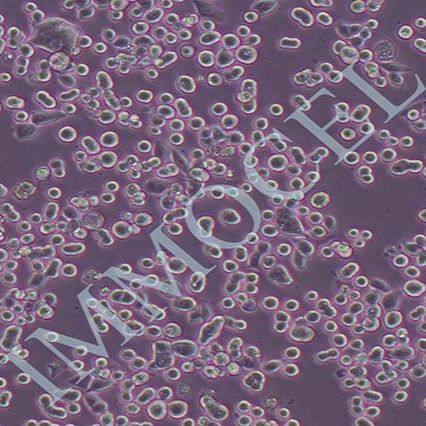
KATO III 人胃癌细胞丨KATO III 细胞株(STR鉴定)

相关产品推荐更多 >
万千商家帮你免费找货
0 人在求购买到急需产品
- 详细信息
- 文献和实验
- 技术资料
- 英文名:
KATO III
- 库存:
9999
- 供应商:
IMMOCELL
- 肿瘤类型:
详询
- 细胞类型:
详询
- 品系:
人源细胞株
- 组织来源:
胃癌
- 相关疾病:
详询
- 物种来源:
人
- 免疫类型:
详询
- 细胞形态:
上皮细胞样
- 是否是肿瘤细胞:
详询
- 器官来源:
详询
- 运输方式:
顺丰快递
- 年限:
永久
- 生长状态:
正常
KATO III 人胃癌细胞
一、细胞介绍
人胃癌细胞KATO III,来源于55岁的亚洲男性的转移性胃癌,来源部位:胸腔积液、锁骨及腋窝淋巴结和道格拉斯氏陷凹(Douglas cul-de-sac)
二、细胞特性
1) 来源:胃癌
2) 形态:上皮细胞样
3) 含量:>1x106
4) 污染:支原体、细菌、酵母和真菌检测为阴性
5) 规格:T25瓶或者1mL冻存管包装
三、运输和保存
1)使用含有优质胎牛血清的2ml冻存管发送存活细胞。
2)收到细胞后,可在1000RPM,常温条件下,离心5min后,于洁净操作台弃去上清,加入推荐使用的培养基后转移至T25培养瓶中培养,传代达到细胞生长状态良好时,再进行冻存。具体操作见细胞培养步骤。
3)收到细胞后请拍照,3天内如果发现污染,请及时拍照与我们联系。
细胞用途:仅供科研使用。
四、细胞接收后的处理
1) 收到细胞后,请检查发货培养瓶的状况,若发现培养瓶破损、有液溢出及细胞有污染,请拍照后及时联系我们。
2) 在显微镜下确认细胞生长状态时,最好在低倍镜(4或5X物镜)下进行,能准确判断细胞的传代密度。看细胞的形态请在10X和20×物镜下,同时给细胞拍照各2-3张(10×,20×都要拍照),作为售后的依据。
3) 观察好细胞状态后,75%酒精消毒瓶壁将T25瓶置于37℃培养箱放置约2-3h。
4) 贴壁细胞:在运输过程中贴壁细胞会有脱落的现象,如发现贴壁细胞有脱落或者脱落后抱团生长,可将T25瓶置于37℃培养箱放置约2-3h,然后抽出瓶中的培养基和未贴壁细胞1000rpm离心5分钟,弃去上清重悬后接种到加有按照说明书细胞培养条件新配制的完全培养基的原培养瓶中(或新的培养瓶中)。
5) 悬浮细胞:T25瓶置于37℃培养箱放置约2-3h,然后抽出瓶中的培养基和细胞1000rpm离心5分钟,弃去上清重悬后接种到新的培养瓶中(加入按照说明书细胞培养条件新配制的完全培养基)。
6)备注:运输用的培养基(灌液培养基)不能再用来培养细胞,请换用按照说明书细胞培养条件新配制的完全培养基来培养细胞。 收到细胞后第一次传代建议1:2传代 。
五、细胞培养步骤
1.培养基及培养冻存条件准备
1) 准备RPMI-1640培养基;优质胎牛血清,10%;双抗,1%。
2) 培养条件: 气相:空气,95%;二氧化碳,5%。 温度:37摄氏度,培养箱湿度为70%-80%。
3) 冻存液:90%血清,10%DMSO,现用现配。
2. 细胞处理
1) 复苏细胞:将含有1mL细胞悬液的冻存管在37℃水浴中迅速摇晃解冻,加入4mL培养基混合均匀。在1000RPM条件下离心4分钟,弃去上清液,补加1-2mL培养基后吹匀。然后将所有细胞悬液加入培养瓶中培养过夜(或将细胞悬液加入250px皿中,加入约8ml培养基,培养过夜)。第二天换液并检查细胞密度。
2) 细胞传代:如果细胞密度达80%-90%,即可进行传代培养。
对于贴壁细胞,传代可参考以下方法
1) 弃去培养上清,用不含钙、镁离子的PBS润洗细胞1-2次。
2) 加2ml消化液(0.25%Trypsin-0.53mM EDTA)于培养瓶中,置于37℃培养箱中消化1-2分钟,然后在显微镜下观察细胞消化情况,若细胞大部分变圆并脱落,迅速拿回操作台,轻敲几下培养瓶后加少量培养基终止消化。
3) 按6-8ml/瓶补加培养基,轻轻打匀后吸出,在1000RPM条件下离心4分钟,弃去上清液,补加1-2mL培养液后吹匀。
4) 将细胞悬液按1:2到1:5的比例分到新的含8ml培养基的新皿中或者瓶中。
注:第一次传代推荐传代比例为1:2,以后传代比例可根据客户需要自己决定。
下面T25瓶为例
1) 细胞冻存时,弃去培养基后,PBS清洗瓶底1-2次后加入1ml胰酶,细胞变圆脱落后,加入2ml完全培养基终止消化,可使用血球计数板计数。
2) 1000RPM离心5分钟去掉上清。用血清重悬浮,加DMSO至最终浓度为10%。加入DMSO后迅速混匀,按每1ml的数量分配到冻存管中,注意冻存管做好标识。本公司按每个冻存管细胞数目大于1X106个细胞冻存。
3) 将冻存管置于程序降温盒中,放入-80度冰箱,至少2个小时以后转入液氮灌储存。记录冻存管位置以便下次拿取。

风险提示:丁香通仅作为第三方平台,为商家信息发布提供平台空间。用户咨询产品时请注意保护个人信息及财产安全,合理判断,谨慎选购商品,商家和用户对交易行为负责。对于医疗器械类产品,请先查证核实企业经营资质和医疗器械产品注册证情况。
文献和实验、 miRNA靶基因的验证与miRNA靶基因 的预测方法相比,对miRNA靶基因进行实验验证的方法并不多,目前还没有一个快速、简便、高通量的鉴定方法。最直接的鉴定方法是, 利用荧光定量PCR及Westernblot方法分别检测转染或敲低miRNA后细胞中mRNA水平及蛋白水平的变化,从而确定miRNA与靶基因的对应关系。这种方法能够直接鉴定出miRNA的靶基因, 准确度高但不能鉴定miRNA的靶位点。转染或敲低miRNA:方式主要有两种,一种是构建miRNA过表达载体的稳定表达系统,一种是人工合成miRNA
BD发布新一代流式细胞仪FACSAria III细胞分选系统
相关专题 实验室的CT-流式细胞仪 美国BD公司的生物科学部门近日宣布推出新一代的流式细胞仪 ——BD FACSAria™ III细胞分选系统,它能够利用6根激光运行复杂的多色实验。自2003年首次推出BD FACSAria以来,这一系列仪器开创了细胞分选的复杂世界,让受众更多,应用范围更广。如今新上市的BD FACSAria III系统更加强大、可靠,且更易用。 BD生物科学细胞分析的总裁James
细胞株名称 ATCC 编号 细胞来源 细胞种类 生长状态 使用培养基293 CRL-1573 人 胎肾 贴壁、上皮样 MEM/NEAA,10%FBS2215 无 人 肝癌 贴壁、上皮样 DMEM,15%FBS127TAg CRL-2817 小鼠 多能胚胎干细胞 胚胎型 DMEM, 10% FBS293/CHE-Fc CRL-2368 人 肾 上皮细胞、贴壁 DMEM,10%FBS3T3-L1 CL-173 小鼠 胚胎成纤维 成纤维 DMEM,10%FBS3T6 CCL-96 小鼠 胚胎 成纤维